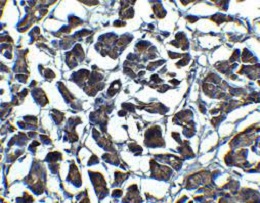
ANTI-IL-23抗体

ANTI-IL-23抗体
Anti-IL-23 Antibody
询价
1mg
起订
上海 更新日期:2026-04-05
产品详情:
- 中文名称:
- ANTI-IL-23抗体
- 英文名称:
- Anti-IL-23 Antibody
- 产品类别:
- 抗体
- 亚型:
- IgG
- 克隆性:
- 多克隆
公司简介
上海一研生物科技有限公司Shanghai yiyan bio-technology Co. Ltd.系集研发、生产销售为- -体的
企业。公司拥有:分子生物学、医学、药学、化学等方面的多名专业技术人员。是数家国外著名生命科学类公司
在中国的指定总进口商及总经销商。公司自成立以来,承"全心全意服务于科研_工作者”的企业理念,立足生物
科技领域,运用生物技术和高新科研试剂,发展现代生物科技,为格大中小医院及其它医疗机构、等院校、
科研院所、企事业单位提供优质的产品,服务生物科技领域的科学研究人员。
我公司拥有多个产品仓库,具有对普通货物、冷藏及冷冻仓库的存储、包装及运输能力。
在市场竞争日益激烈的今天,我公司将始终坚持信誉立业、以以为本、质量率先、诚信服务的宗旨,不断拼搏,
开拓进取,与各界朋友携手共创美好未来。
| 成立日期 | (12年) |
| 注册资本 | 100万人民币 |
| 员工人数 | 1-10人 |
| 年营业额 | ¥ 100万-300万 |
| 经营模式 | 贸易,试剂 |
| 主营行业 | 生物化工,化学试剂 |
ANTI-IL-23抗体相关厂家报价
-

- ANTI-IL-23抗体
- 上海茁彩生物科技有限公司
- 2026-04-05
- 询价
-

- 抑制剂多肽IL-23R inhibitor peptide-1/2894052-23-2/IL-23R inhibitor peptide-1
- 南京肽研生物科技有限公司 VIP
- 2026-04-13
- ¥2500
-

- 人白介素12 p40(IL-12;IL-23 p40)elisa试剂盒
- 上海臻科生物科技有限公司 VIP
- 2026-04-13
- ¥1280
-

- 人白介素12 p40(IL-12;IL-23 p40)ELISA试剂盒
- 上海研启生物科技有限公司 VIP
- 2026-04-13
- ¥1280